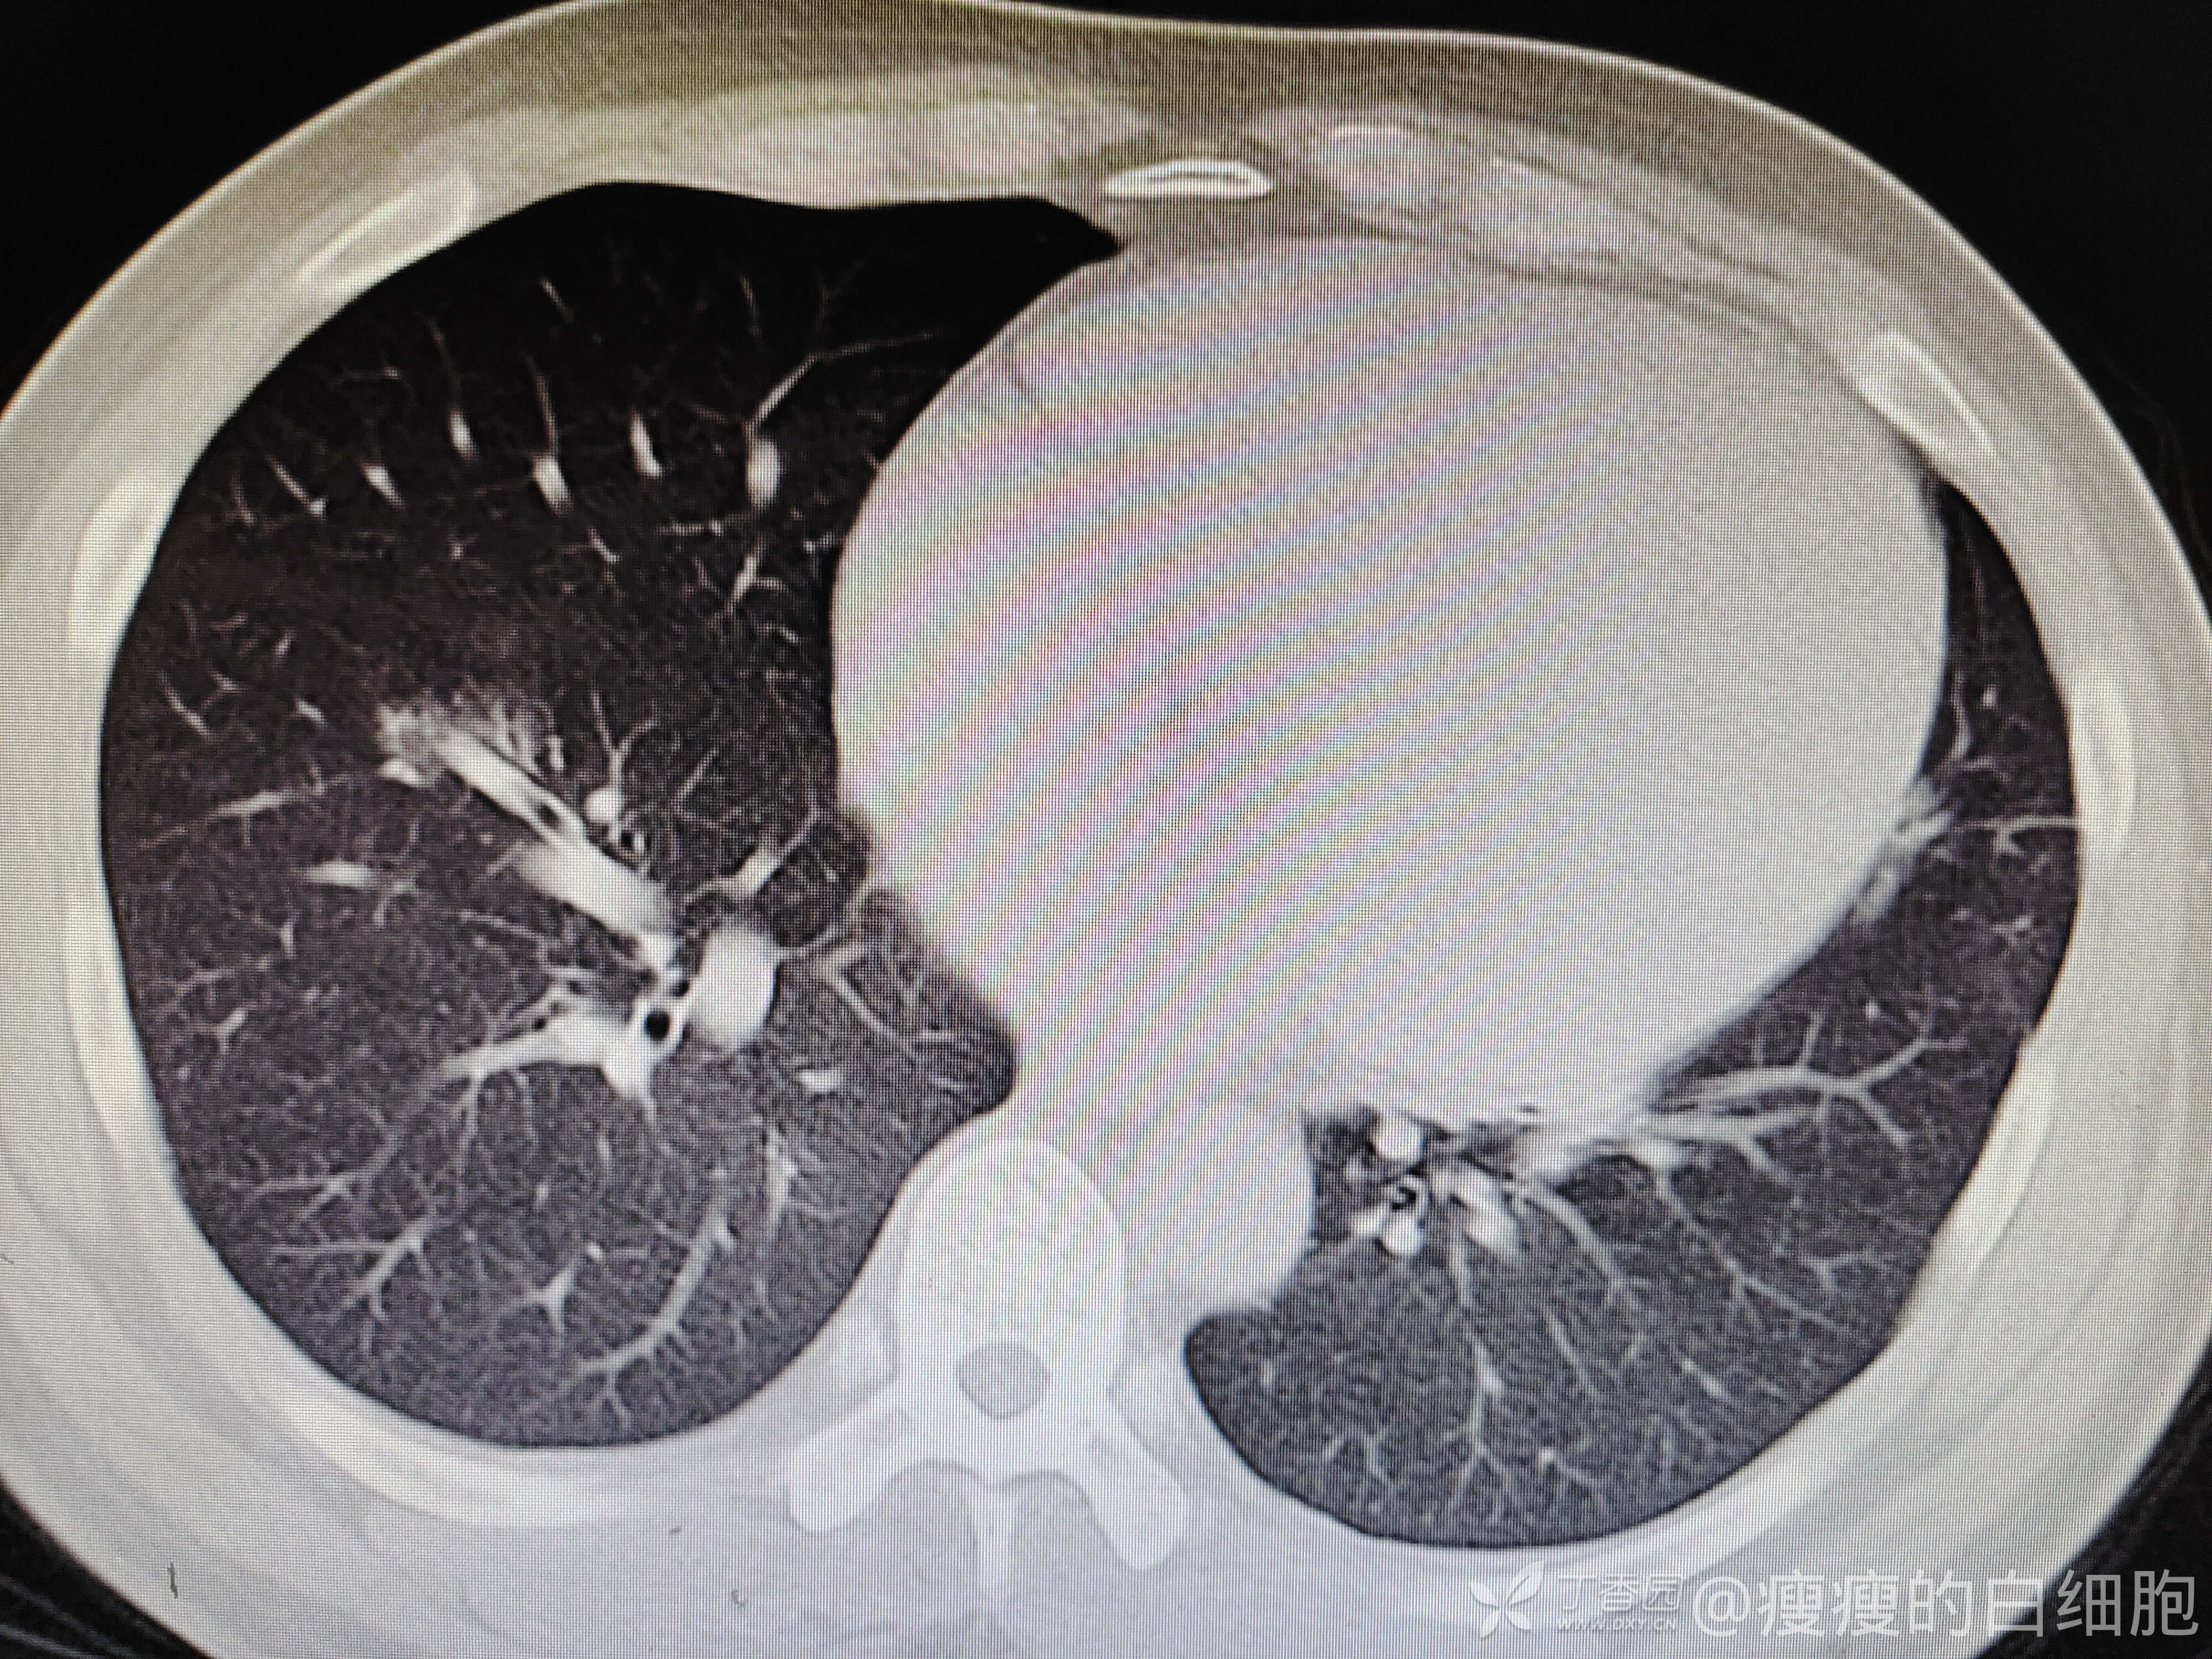
img
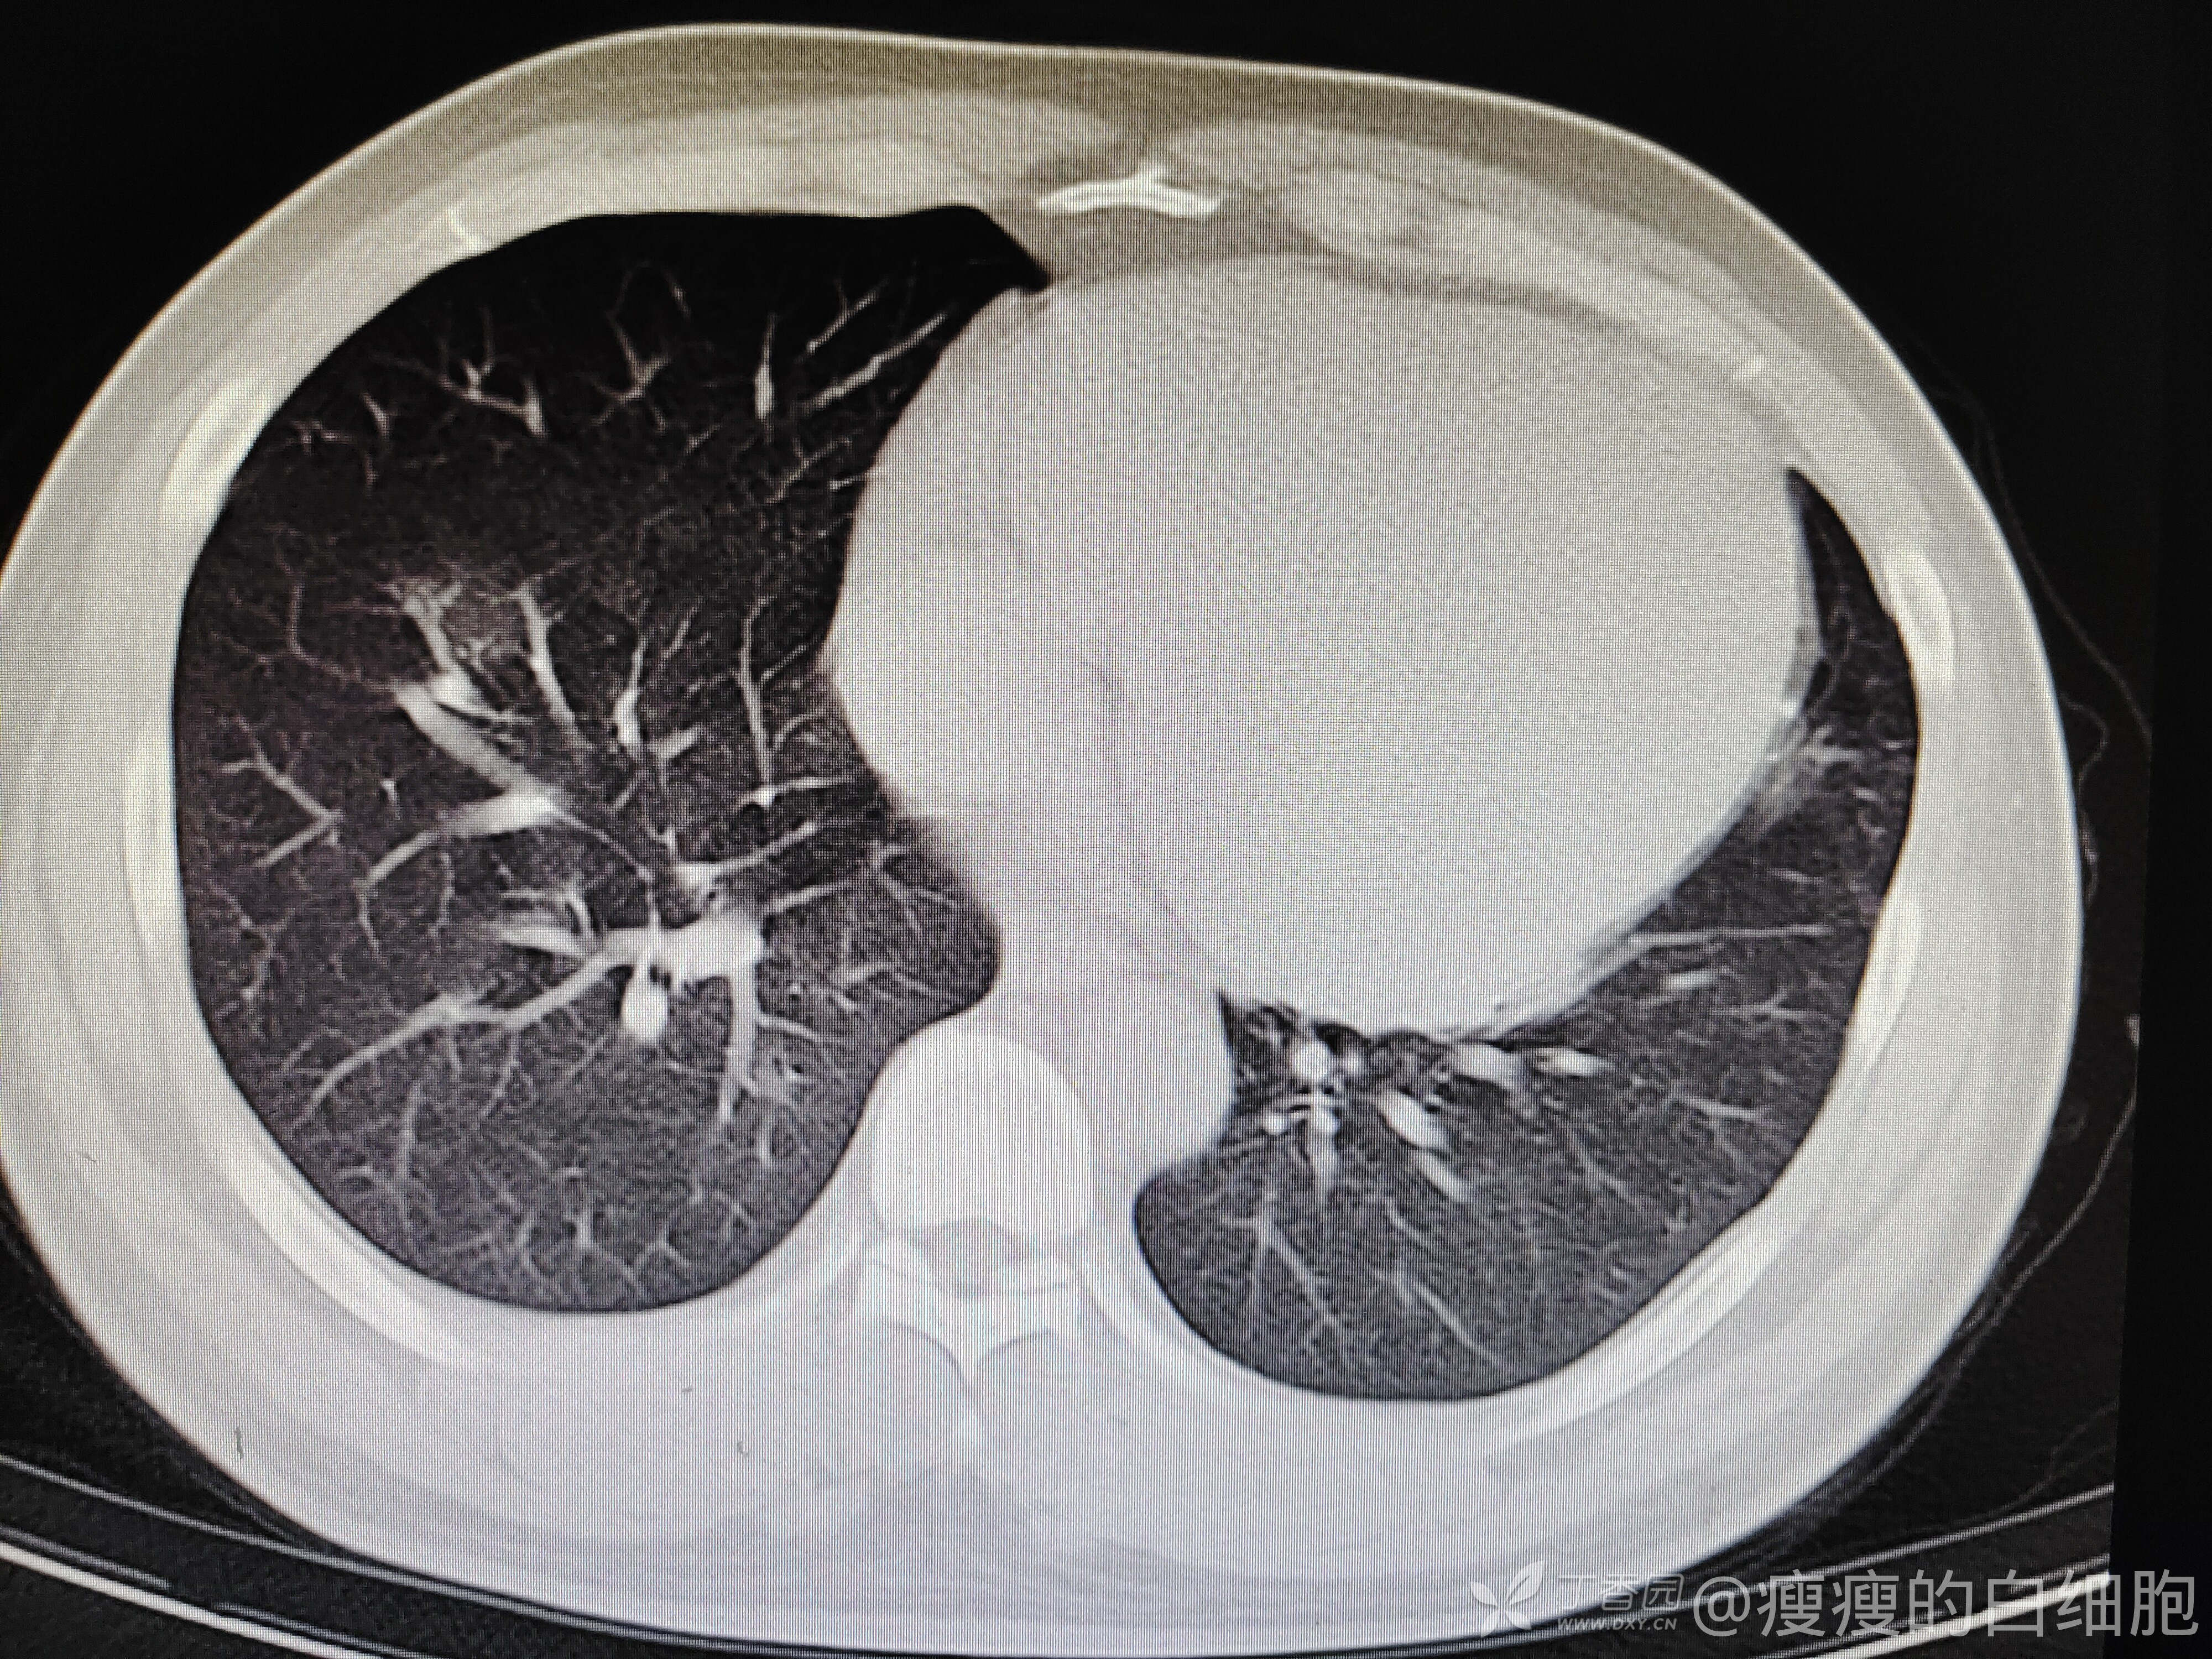
img

年轻小伙肺炎抗感染后症状加重,什么原因?
 西门开心 推荐
西门开心 推荐男子,35岁,因为咳嗽半月来诊,门诊抗感染治疗5天。既往有高血压病史,未治疗,入院时血常规及胸部CT如下

5天后咳嗽略减轻,但感胸闷。这时候血压达到了169/126mmhg,查体肺部无干湿性啰音,下肢也无水肿。再次复查胸部CT


新发病毒感染?还是心衰?继续完善检查,心电图大致正常。




好家伙,NT-pro-BNP这么高,心衰无疑了,给予降压、利尿、补钾等治疗后症状减轻,建议出院后继续口服利尿剂、抗生素后复查相关指标。
总结分析:1.对于年轻患者,我们容易忽视血压的问题,这个病人也是后来追问病史才知道血压平时就高的;
2.这人为什么会心衰?高血压控制不好?输液过快?(每日输液450ml)感染诱发?
















































